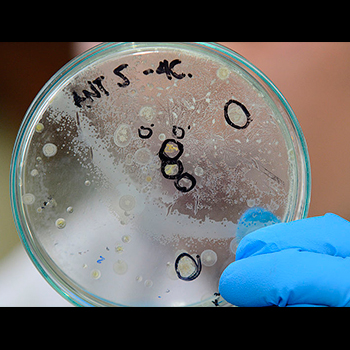

Microorganismos de la Antártida permitirían cultivar suelos infértiles
Muestras de estos microorganismos, recolectados durante la segunda expedición a la Antártida realizada por la Universidad Nacional de Colombia (U.N.), son estudiadas con el fin de mejorar las condiciones de siembra en regiones desérticas como La Guajira.
“Desarrollamos nuestro trabajo a principios de 2016 en una pequeña isla conocida como Media Luna, que forma parte de la península Antártica, en las islas Shetland del sur”, destaca la profesora María Angélica Leal, del Grupo de Ciencias Planetarias y Astrobiología (GCPA).

Teniendo en cuenta que en la superficie solo habría una capa de hielo y por debajo de los 15 cm solo se encontrarían organismos anaeróbicos, durante la expedición se tomaron muestras de sedimentos que se encontraban entre estos rangos de profundidad, utilizando una pala estéril y bolsas que impidieran su contaminación, además de conservar la cadena de frío.
“Si la muestra no se mantiene congelada, el microorganismo continúa su proceso hasta que se degrada”, subraya la investigadora, quien precisa que los sedimentos son producto de un proceso de desgaste de las rocas que se encuentran en la zona, debido a su erosión.
De vuelta a los laboratorios de la U.N., las muestras se disuelven en una solución salina estéril que incluye un proceso conocido como “series de dilución”, en el que se van transfiriendo pequeñas cantidades en múltiples recipientes hasta obtener una cantidad más limitada de bacterias para facilitar su conteo.
Mientras que en muestras de suelo locales se alcanzaba a llegar hasta el tubo 13, en las muestras recogidas en la Antártida escasamente se llegaba a cuatro, prueba de la escasa cantidad de microorganismos capaces de resistir condiciones tan extremas.
Una vez finalizada esta fase de la investigación se hizo un cultivo de las muestras con temperaturas iniciales de 4 oC, que después debieron pasar a 15 oC, con el fin de agilizar el proceso de análisis.
Microorganismos funcionales
Como resultado de este trabajo se obtuvieron 98 diferentes morfotipos de estos microorganismos, cuya apariencia variaba según su color, elevación, textura y tonalidad.
A partir de un procedimiento conocido como “tinción de Gram”, se evaluó la pared celular con el fin de continuar con pruebas específicas para establecer su género y potencial en múltiples procesos.
Pruebas para determinar la capacidad de solubilizar fosfato, fijar nitrógeno y otras seis actividades implicadas en los ciclos del nitrógeno, el fósforo y el carbono, permitieron establecer que 96 de estos microorganismos podrían ser de gran ayuda para el crecimiento vegetal.

Debido a la imposibilidad de cultivar algunos de los microorganismos encontrados, el GCPA trabaja en la elaboración de modelos matemáticos junto con la profesora Valérie Gauthier Umaña, de la Universidad del Rosario, con el propósito de establecer comparaciones con otros lugares.
“La importancia de estos modelos es que al enviar una sonda a otro planeta, esta podrá identificar vida, gracias a que cuenta con unos patrones que le permitirán hacer estas comparaciones”, precisa la investigadora.
La investigación de las docentes Luz Marina Melgarejo y María Angélica Leal involucró el trabajo conjunto entre el GCPA y el grupo de Fisiología del estrés y biodiversidad en plantas y microorganismos, con participación de la profesora Ximena Sánchez, y la colaboración de Elkin Marcelo Ruiz, Alexis Infante y Óscar Barriga.

Fuente:
UNAL